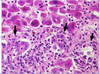

Pathology- Misc liver and GI diseases Flashcards
(34 cards)
what can cause conjugated/direct jaundice?
- obstruction, hepatitis, dubin-johnson
what can cause unconjugated/indirect jaundice?
- hemolysis, hepatitis, gilbert
why is jaundice common in neonates?
d/t liver immaturity (hepatic machinery for conjugating and excreting bilirubin not fully operational until 2 weeks old)
what can severe hyperbiliruninemia do and how can it be tx?
- injures brain and tx with UV lights
what is the most common cause of death from liver disease in early childhood?
- biliary atresia- progressive inflammatory and firbosing disease of extrahepatic bile duct –> complete obstruction of bile flow caused by destruction of extrahepatic bile ducts
- causes 1/3 of neonatal choelstasis.
what is this?
biliary atresia- fibrosing obliterating an extrahepatic bile duct
How do patients with bilairy atresia present?
- jaundiced at 3-6 weeks of age
- have conjugated hyperbilirubninemia
lab values for biliary atretic patient?
- disproportionately high GGT
- mild-mod high ALT and AST
- poor prognosis improved by early surgery (hepatoportoenterostomy) but many still need liver transplant
**alk phos in children is more from bone so less useful in diagnosing liver disease.
Alagille syndrome presentation?
- neonatal jaundice, pruritis, and cholestasis plus a bunch of other stuff like triangular face etc.
- it’s a syndromic paucity of intrahepatic bile ducts
Genetics of alagille syndrome (arteriohepatic dysplasia)?
- AD
- 70% sporadic new mutations
- d/t mutation in JAGGED 1 gene for ligand for NOTCH 1 receptor
what is this?
alagille syndrome. trichrome stain of portal triad blood vessels but no bile ducts
- pronosis for prolonged survival good unless misdiagnosed and surgerized.
Dubin-Johnson sydrome
- hereditary conjugated hyperbiliruniemia
- defective excretion of bilirubin conjugates and other organic anions across hepatocyte canalicular membrane
brown black pigment in liver = lysosomes containing polymers of epinephrine metabolites
presentation of dubin-johnson syndrome?
- usually asymptomatic but may have recurring or fluctuating chronic jaundice
- normal life expectancy
Gilbert syndrome
- AR deficiency of uridinge diphosphate glucuronyltransferase (UGT) enzyme that conjugates bilirubin
males > females
presentation of gilbert syndrome?
young adult w/ mild primarily unconjugated hyperbilirubinemia (brought on by febrile illness, physical exertion, fasting, or hemolysis) and no other manifestations
prognosis of gilbert syndrome?
- benign prognosis may even be better than avg bc pts with gilbert syndrome run a slightly higher bilirubin than avg and incidence of colon cancer mortality in general and atherosclerotic heart disease are inversely proportional to bilirubin level so good!!
Primary biliary cirrhosis
- autoimmune slowly progressive cholestatic disease
- female > male
- late to middle aged women
presentation of primary biliary cirrhosis?
pruritis, fatigue, hepatomegaly
- elevated alk phosphate
- eventually get jaundice, xanthomas, steatorrhea
pathology of primary biliary cirrhosis?
- dense lymphocytic infiltrate in and around interlobular bile ducts w/ granulomas and bile duct destruction and loss and progressive portal fibrosis
anti-mitochondrial antibodies associated with what?
primary biliary cirrhosis
what is this?
primary biliary cirrhosis- end stage cirrhosis w/ severe cholestasis
budd chiari syndrome
- portal htn d/t thrombosis of hepatic veins
manifestation of budd- chiari syndrome
hepatomegaly, ascites, abd pain
what causes budd-chiari syndrome?
- polycythemia vera, other myeloproliferative disease, pregnancy, postpartum state, OCP, paroxysmal nocturnal hemoglobunuria, abd cancer esp within the liver itself